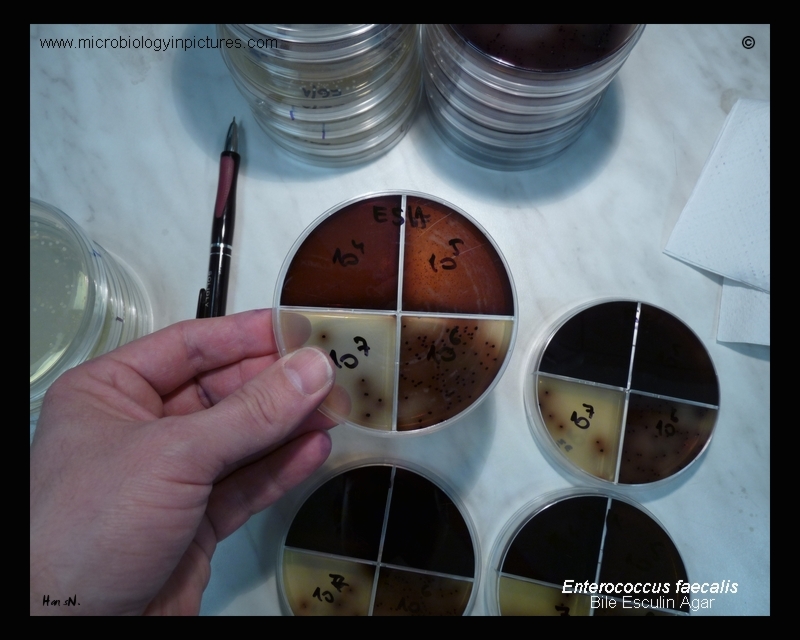

Enterococcus faecalis colonies on bile esculin agar. The ability to hydrolyze esculin in the presence of bile is a characteristic of enterococci and group D streptococci.
Esculin hydrolysis is resulting in the blackening of the medium. Bile salts inhibit gram-positive bacteria other than enterococci.
Cultivated 24 hours at 37°C in an aerobic atmosphere.